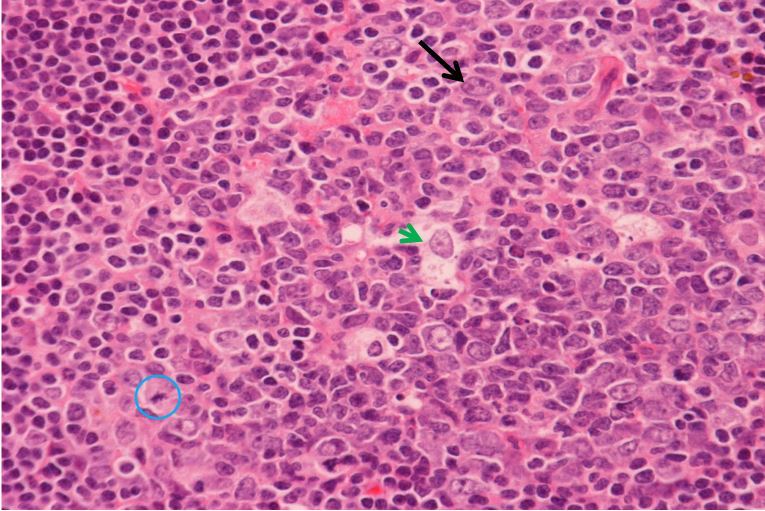

Anterior cervical triangle borders - boundaries: anterior, posterior, superior, apex, floor, roof
- anterior: median line of the neck. -posterior: anterior border of the SCM. - superior: inferior border of the mandible. -apex: jugular notch in the manubrium. -roof: subcutaneous tissue containing the platysma. -floor: pharynx, larynx, and thyroid gland.
submental triangle - borders - contents
- inferior: body of hyoid - lateral: R & L anterior bellies of digastric - floor: mylohyoid - apex: mandibular symphysis - contains several small submental lymph nodes and small veins that unite to form the anterior jugular vein
submandibular triangle
- superior: inferior border of mandible - anterior: anterior belly of digastric - posterior: posterior belly of digastric - floor: mylohyoid hypoglossus, middle pharyngeal constrictor - contains the submandibular gland and lymph nodes, hypoglossal nerve, mylohyoid nerve, parts of facial artery and vein
carotid triangle - borders - contents
- anterior: superior belly of omohyoid - posterior: anterior border of SCM - superior: posterior belly of digastric - contents: carotid sheath (common carotid, IJV, and vagus), external carotid, hypoglossal nerve, ansa cervicalis, spinal accessory, thyroid gland and deep cervical lymph nodes
Located within the carotid triangle
• Carotid sinus: a dilation of the proximal part of the internal carotid artery which may involve the common carotid artery. Innervated principally by the glossopharyngeal nerve (CN IX) through the carotid sinus nerve as well as by the vagus nerve (CN X), it is a baroreceptor (pressoreceptor) that reacts to changes in arterial blood pressure. • Carotid body: a small, reddish brown ovoid mass of tissue lies in a septum on the medial (deep) side of the bifurcation of the common carotid artery in close relation to the carotid sinus. Supplied mainly by the carotid sinus nerve (CN IX) and by CN X, it is a chemoreceptor that monitors the level of oxygen in the blood. It is stimulated by low levels of oxygen and initiates a reflex that increases the rate and depth of respiration, cardiac rate, and blood pressure.
muscular triangle
- posterior: omohyoid - anterior: midline of neck - inferior: anterior border of SCM - contents: sternothyroid and sternohyoid, thyroid, parathyroid
hyoid muscles - where are they found -primary function -two subdivisions
- steady or move the hyoid and larynx -divided into suprahyoid and infrahyoid muscles - found superior and inferior to the hyoid
internal carotid arteries
- direct continuations of the common carotids superior to the origin of the external carotid artery -enter the cranium through the carotid canals in the petrous parts of the temporal bones and become the main arteries of the brain and structures in the orbits
external carotid arteries
-supply most structures external to the cranium -embedded in the parotid gland, and terminates by dividing into two branches, the maxillary artery and the superficial temporal artery
IJV
- IJV drains blood from the brain, anterior face, cervical viscera, and deep muscles of the neck - vein lies laterally within the carotid sheath, with the vagus nerve located posteriorly.
superior bulb of the IJV
dilation at its origin
inferior bulb of the IJV.
-nferior end of the IJV dilates -has a bicuspid valve that permits blood to flow toward the heart while preventing backflow into the vein, as might occur if inverted
inferior petrosal sinus
leaves the cranium through the jugular foramen and enters the superior bulb of the IJV
Lymph drainage of the neck
-parotid nodes/posterior auricular nodes/ occipital noedes to superficial cervical lymph nodes to deep cervical lymph nodes to right lymphatic duct or thoracic duct -submental and submandibular nodes go directly to deep cervical lymph nodes and then to right lymphatic duct or thoracic duct
posterior triangle borders
Anterior: posterior border of SCM Posterior: anterior border of trap Inferior: middle 1/3 of clavicle Apex: sup, nuchal line Roof: investing layer of deep fascia flood: prevertebral fascia
Torticollis
-observed in children -lateral flexion and rotation of the head and neck -fibrosis of SCM
Nerves found in the posterior triangle
-XI - cervical plexus: cutaneous -brachial plexus: roots and trunks
Arteries found in the posterior triangle
-lateral branch of thyrocervical trunk (suprascapular, transverse cervical artery) -3rd part of subclavian artery -part of occipital artery
Veins found in the posterior triangle
-external jugular: drains the posterior auricular and retromandibular into the subclavian
lymph flow in posterior triangle
-into superficial cervical nodes in the EJV and SCM and then deep cervical nodes
what is this? - presentation? - causes?

- hyperplastic lymphnode - swollen lymph node - bacterial infection
what is this?

acute lymphadenitis
What is this?

- green in secondary lymph follicles
- pink is primary lymph follicles
Identify
- black arrow: centroblast (an actively proliferating B cell)
- green arrow: tingible body (macrophage, clean up b cells that apoptoses)
- blue circle: mitoses ( b cells undergoing proliferation)


